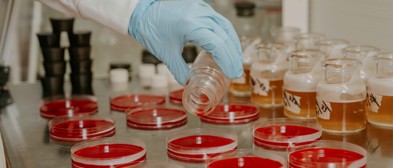
About Us

About Us
Mast Group is a trusted provider of in-vitro diagnostic solutions. As an independent company, since 1959, our commitment to maintaining integrity and customer satisfaction, combined with innovation in in-vitro diagnostics, has resulted in improved clinical decisions and pathways. We recognise our responsibility to provide reliable, fit for purpose in-vitro diagnostics in every community globally.
Watch our corporate video to learn more about Mast Group

As one of the early pioneers of the AST disc, our expertise has evolved from susceptibility, identification and resistance to creating innovative diagnostic solutions, which have improved clinical decisions and pathways. We work with global pharmaceutical companies to utilise our diagnostic expertise in supporting their introduction of essential new antimicrobial compounds in an ever-changing AMR landscape.

We understand the importance of technical customer support and our facilities enable us to hold in-person training and demonstrations. We also hold regular conferences, bringing Key Opinion Leaders together to ensure our customers remain up to date with the management of clinical pathways. Building these strong relationships has resulted in work with key trusts and charities to produce an award-winning aid that supports the usability and accessibility of diagnostic test for all.
Discover Mast Group












Our Partners
Collaboration with trusted distributors and research institutions worldwide.






Our Locations
Mast Group has a number of specialist sites spread across the north west dedicated to providing excellent service and customer support.


